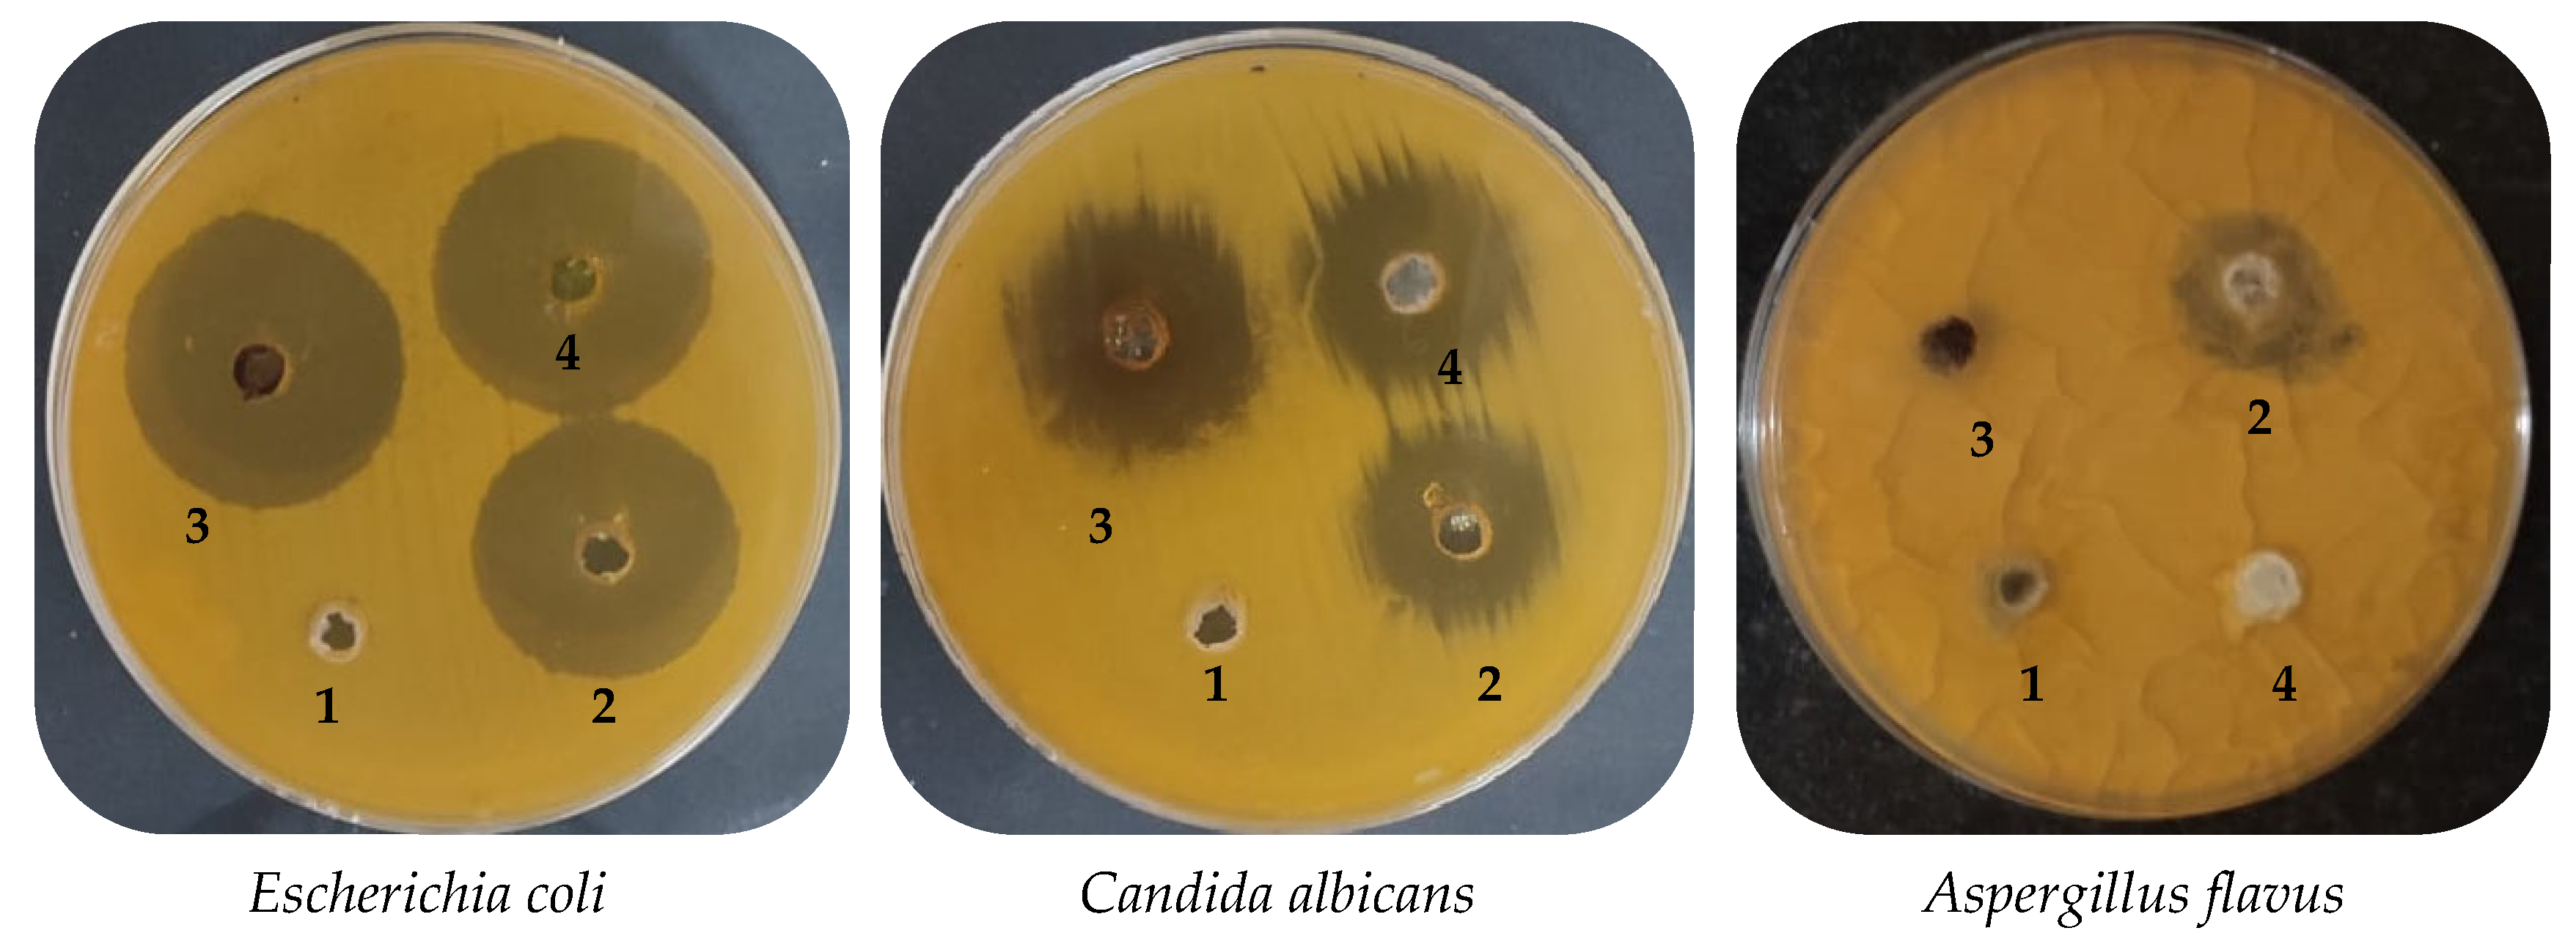

Phytochemical Characterization of Saudi Mint and Its Mediating Effect on the Production of Silver Nanoparticles and Its Antimicrobial and Antioxidant Activities
Abstract
1. Introduction
2. Results and Discussion
2.1. Phenolic and Flavonoid Characterizations of Mint Extract (ME)
2.2. Characterization of Phyto-Created AgNPs by Mint Plant (ME)
2.3. Antimicrobial Activity of Mint Extract and Phyto-Created AgNPs
2.4. Antioxidant Activity of Mint Extract and Phyto-Created AgNPs
3. Materials and Methods
3.1. Chemicals Used in the Study
3.2. Collection and Extraction of the Mint Plant
3.3. Detection of the Phenolic and Flavonoid Constituents of Mint Extract via HPLC
3.4. Synthesis of Silver Nanoparticles (AgNPs)
3.5. Characterization of Synthesized AgNPs
3.6. Antimicrobial Activity of Mint Extract and AgNPs Using Agar Diffusion Method
3.7. The Minimal Inhibitory Concentration (MIC) Experiment
3.8. The Minimal Bactericidal Concentration (MBC) Experiment
3.9. The Antioxidant Activity of the Mint Extract and AgNPs
3.10. Statistical Analysis
4. Conclusions
Supplementary Materials
Author Contributions
Funding
Data Availability Statement
Acknowledgments
Conflicts of Interest
References
- Shahbazi, Y. Application of carboxymethyl cellulose and chitosan coatings containing Mentha spicata essential oil in fresh strawberries. Int. J. Biol. Macromol. 2018, 112, 264–272. [Google Scholar] [CrossRef] [PubMed]
- Sarikurkcu, C.; Eryigit, F.; Cengiz, M.; Tepe, B.; Cakir, A.; Mete, E. Screening of the Antioxidant Activity of the Essential Oil and Methanol Extract of Mentha pulegium L. from Turkey. Spectrosc. Lett. 2012, 45, 352–358. [Google Scholar] [CrossRef]
- Božović, M.; Pirolli, A.; Ragno, R. Mentha suaveolens Ehrh. (Lamiaceae) Essential Oil and Its Main Constituent Piperitenone Oxide: Biological Activities and Chemistry. Molecules 2015, 20, 8605–8633. [Google Scholar] [CrossRef] [PubMed]
- Dwivedy, A.K.; Prakash, B.; Chanotiya, C.S.; Bisht, D.; Dubey, N.K. Chemically characterized Mentha cardiaca L. essential oil as plant based preservative in view of efficacy against biodeteriorating fungi of dry fruits, aflatoxin secretion, lipid peroxidation and safety profile assessment. Food Chem. Toxicol. 2017, 106, 175–184. [Google Scholar] [CrossRef] [PubMed]
- Aldogman, B.; Bilel, H.; Moustafa, S.M.N.; Elmassary, K.F.; Ali, H.M.; Alotaibi, F.Q.; Hamza, M.; Abdelgawad, M.A.; El-Ghorab, A.H. Investigation of Chemical Compositions and Biological Activities of Mentha suaveolens L. from Saudi Arabia. Molecules 2022, 27, 2949. [Google Scholar] [CrossRef]
- Ahmed, A.M.; Ozbak, H.A.; Hemeg, H.A. Effect of essential oil of traditional two Saudi mint types and its possible role in cardiovascular and throat health. Int. J. Clin. Exp. Med. 2015, 8, 8060–8068. [Google Scholar]
- Anwar, F.; Abbas, A.; Mehmood, T.; Gilani, A.-H.; Rehman, N.-U. Mentha: A genus rich in vital nutra-pharmaceuticals—A review. Phytother. Res. 2019, 33, 2548–2570. [Google Scholar] [CrossRef]
- Burham, B.O.; Osman, O.A.; Nour, A.A.M. Chemical Composition and Antibacterial Activity of Essential oil of Mentha longifolia Leaf from Albaha Area Southern Saudi Arabia. Asian J. Biol. Life Sci. 2019, 8, 48–52. [Google Scholar] [CrossRef]
- Ibrahim, S.R.M.; Abdallah, H.M.; Mohamed, G.A.; Farag, M.A.; Alshali, K.Z.; Alsherif, E.A.; Ross, S.A. Volatile oil profile of some lamiaceous plants growing in Saudi Arabia and their biological activities. Z. Nat. C 2017, 72, 35–41. [Google Scholar] [CrossRef]
- El-Sayeda, A.E.-K.; Hesham, I.E.-A.; Zeinab, A.K.; Shahira, M.E.; Mohamed, A.S.; Amany, A.S. Chemical and biological study of Mentha suaveolens Ehrh. Cultivated in Egypt. J. Med. Plant Res. 2014, 8, 747–755. [Google Scholar] [CrossRef]
- El-Kashoury, E.-S.A.; El-Askary, H.I.; Kandil, Z.; Salem, M.A.; Sleem, A.A. Chemical composition and biological activities of the essential oil of Mentha suaveolens Ehrh. Z. Nat. C J. Biosci. 2012, 67, 571–579. [Google Scholar] [CrossRef]
- Farnad, N.; Heidari, R.; Aslanipour, B. Phenolic composition and comparison of antioxidant activity of alcoholic extracts of Peppermint (Mentha piperita). J. Food Meas. Charact. 2014, 8, 113–121. [Google Scholar] [CrossRef]
- Zekri, N.; Elazzouzi, H.; Ailli, A.; Gouruch, A.A.; Radi, F.Z.; El Belghiti, M.A.; Zair, T.; Nieto, G.; Centeno, J.A.; Lorenzo, J.M. Physicochemical Characterization and Antioxidant Properties of Essential Oils of M. pulegium (L.), M. suaveolens (Ehrh.) and M. spicata (L.) from Moroccan Middle-Atlas. Foods 2023, 12, 760. [Google Scholar] [CrossRef]
- Bayda, S.; Adeel, M.; Tuccinardi, T.; Cordani, M.; Rizzolio, F. The History of Nanoscience and Nanotechnology: From Chemical-Physical Applications to Nanomedicine. Molecules 2020, 25, 112. [Google Scholar] [CrossRef]
- Abdelghany, T.M. Stachybotrys chartarum: A Novel Biological Agent for The Extracellular Synthesis of Silver Nanoparticles and Their Antimicrobial Activity. Indones. J. Biotechnol. 2015, 18, 75. [Google Scholar] [CrossRef]
- Yahya, R.; Al-Rajhi, A.M.H.; Alzaid, S.Z.; Al Abboud, M.A.; Almuhayawi, M.S.; Al Jaouni, S.K.; Selim, S.; Ismail, K.S.; Abdelghany, T.M. Molecular Docking and Efficacy of Aloe vera Gel Based on Chitosan Nanoparticles against Helicobacter pylori and Its Antioxidant and Anti-Inflammatory Activities. Polymers 2022, 14, 2994. [Google Scholar] [CrossRef]
- Al-Rajhi, A.M.H.; Yahya, R.; Bakri, M.M.; Yahya, R.; Abdelghany, T.M. In situ green synthesis of Cu-doped ZnO based polymers nanocomposite with studying antimicrobial, antioxidant and anti-inflammatory activities. Appl. Biol. Chem. 2022, 65, 35. [Google Scholar] [CrossRef]
- Qanash, H.; Bazaid, A.S.; Aldarhami, A.; Alharbi, B.; Almashjary, M.N.; Hazzazi, M.S.; Felemban, H.R.; Abdelghany, T.M. Phytochemical Characterization and Efficacy of Artemisia judaica Extract Loaded Chitosan Nanoparticles as Inhibitors of Cancer Proliferation and Microbial Growth. Polymers 2023, 15, 391. [Google Scholar] [CrossRef]
- Abdelghany, T.M.; Al-Rajhi, A.M.H.; Al Abboud, M.A.; Alawlaqi, M.M.; Ganash Magdah, A.; Helmy, E.A.M.; Mabrouk, A.S. Recent Advances in Green Synthesis of Silver Nanoparticles and Their Applications: About Future Directions. A Review. BioNanoScience 2018, 8, 5–16. [Google Scholar] [CrossRef]
- Abdelghany, T.; Yahya, R.; Bakri, M.M.; Ganash, M.; Amin, B.H.; Qanash, H. Effect of Thevetia peruviana seeds extract for microbial pathogens and cancer control. Int. J. Pharmacol. 2021, 17, 643–655. [Google Scholar] [CrossRef]
- Al-Rajhi, A.M.H.; Qanash, H.; Almuhayawi, M.S.; Al Jaouni, S.K.; Bakri, M.M.; Ganash, M.; Salama, H.M.; Selim, S.; Abdelghany, T.M. Molecular Interaction Studies and Phytochemical Characterization of Mentha pulegium L. Constituents with Multiple Biological Utilities as Antioxidant, Antimicrobial, Anticancer and Anti-Hemolytic Agents. Molecules 2022, 27, 4824. [Google Scholar] [CrossRef] [PubMed]
- Al-Rajhi, A.M.H.; Yahya, R.; Abdelghany, T.M.; Fareid, M.A.; Mohamed, A.M.; Amin, B.H.; Masrahi, A.S. Anticancer, Anticoagulant, Antioxidant and Antimicrobial Activities of Thevetia peruviana Latex with Molecular Docking of Antimicrobial and Anticancer Activities. Molecules 2022, 27, 3165. [Google Scholar] [CrossRef] [PubMed]
- Al-Rajhi, A.M.H.; Qanash, H.; Bazaid, A.S.; Binsaleh, N.K.; Abdelghany, T.M. Pharmacological Evaluation of Acacia nilotica Flower Extract against Helicobacter pylori and Human Hepatocellular Carcinoma In Vitro and In Silico. J. Funct. Biomater. 2023, 14, 237. [Google Scholar] [CrossRef] [PubMed]
- Kamatou, G.P.; Vermaak, I.; Viljoen, A.M.; Lawrence, B.M. Menthol: A simple monoterpene with remarkable biological properties. Phytochemistry 2013, 96, 15–25. [Google Scholar] [CrossRef]
- Sivakumar, T.R.T.; Thangapandian, V.; Shankar, T. Silver Nanoparticles Synthesis of Mentha arvensis Extracts and Evaluation of Antioxidant Properties. J. Biosci. Bioeng. 2015, 1, 22–28. [Google Scholar]
- Rizwana, H.; Alwhibi, M.S. Biosynthesis of silver nanoparticles using leaves of Mentha pulegium, their characterization, and antifungal properties. Green Process. Synth. 2021, 10, 824–834. [Google Scholar] [CrossRef]
- Chung, I.-M.; Park, I.; Seung-Hyun, K.; Thiruvengadam, M.; Rajakumar, G. Plant-Mediated Synthesis of Silver Nanoparticles: Their Characteristic Properties and Therapeutic Applications. Nanoscale Res. Lett. 2016, 11, 40. [Google Scholar] [CrossRef]
- Ali, K.; Ahmed, B.; Dwivedi, S.; Saquib, Q.; Al-Khedhairy, A.A.; Musarrat, J. Microwave Accelerated Green Synthesis of Stable Silver Nanoparticles with Eucalyptus globulus Leaf Extract and Their Antibacterial and Antibiofilm Activity on Clinical Isolates. PLoS ONE 2015, 10, e0131178. [Google Scholar] [CrossRef]
- Das, B.; Dash, S.K.; Mandal, D.; Ghosh, T.; Chattopadhyay, S.; Tripathy, S.; Das, S.; Dey, S.K.; Das, D.; Roy, S. Green synthesized silver nanoparticles destroy multidrug resistant bacteria via reactive oxygen species mediated membrane damage. Arab. J. Chem. 2017, 10, 862–876. [Google Scholar] [CrossRef]
- Ganash, M.; Ghany, T.M.A.; Omar, A.M. Morphological and Biomolecules Dynamics of Phytopathogenic Fungi under Stress of Silver Nanoparticles. BioNanoScience 2018, 8, 566–573. [Google Scholar] [CrossRef]
- Bakri, M.M.; El-Naggar, M.A.; Helmy, E.A.; Ashoor, M.S.; Ghany, T.M.A. Efficacy of Juniperus procera Constituents with Silver Nanoparticles Against Aspergillus fumigatus and Fusarium chlamydosporum. BioNanoScience 2020, 10, 62–72. [Google Scholar] [CrossRef]
- Yan, Y.; Li, Q.; Shen, L.; Guo, K.; Zhou, X. Chlorogenic acid improves glucose tolerance, lipid metabolism, inflammation and microbiota composition in diabetic db/db mice. Front. Endocrinol. 2022, 13, 1042044. [Google Scholar] [CrossRef]
- Choi, S.S.; Park, H.R.; Lee, K.A. A Comparative Study of Rutin and Rutin Glycoside: Antioxidant Activity, Anti-Inflammatory Effect, Effect on Platelet Aggregation and Blood Coagulation. Antioxidants 2021, 10, 1696. [Google Scholar] [CrossRef]
- Khan, H.; Ullah, H.; Aschner, M.; Cheang, W.S.; Akkol, E.K. Neuroprotective Effects of Quercetin in Alzheimer’s Disease. Biomolecules 2019, 10, 59. [Google Scholar] [CrossRef]
- Bhatiya, M.; Pathak, S.; Jothimani, G.; Duttaroy, A.K.; Banerjee, A. A Comprehensive Study on the Anti-cancer Effects of Quercetin and Its Epigenetic Modifications in Arresting Progression of Colon Cancer Cell Proliferation. Arch. Immunol. Ther. Exp. 2023, 71, 6. [Google Scholar] [CrossRef]
- Díaz-Gómez, R.; López-Solís, R.; Obreque-Slier, E.; Toledo-Araya, H. Comparative antibacterial effect of gallic acid and catechin against Helicobacter pylori. LWT—Food Sci. Technol. 2013, 54, 331–335. [Google Scholar] [CrossRef]
- Bai, J.; Zhang, Y.; Tang, C.; Hou, Y.; Ai, X.; Chen, X.; Zhang, Y.; Wang, X.; Meng, X. Gallic acid: Pharmacological activities and molecular mechanisms involved in inflammation-related diseases. Biomed. Pharm. 2021, 133, 110985. [Google Scholar] [CrossRef]
- Sharifi-Rad, J.; Quispe, C.; Castillo, C.M.S.; Caroca, R.; Lazo-Vélez, M.A.; Antonyak, H.; Polishchuk, A.; Lysiuk, R.; Oliinyk, P.; De Masi, L.; et al. Ellagic Acid: A Review on Its Natural Sources, Chemical Stability, and Therapeutic Potential. Oxidative Med. Cell. Longev. 2022, 2022, 3848084. [Google Scholar] [CrossRef]
- Jan, R.; Khan, M.; Asaf, S.; Lubna; Asif, S.; Kim, K.M. Bioactivity and Therapeutic Potential of Kaempferol and Quercetin: New Insights for Plant and Human Health. Plants 2022, 11, 2623. [Google Scholar] [CrossRef] [PubMed]
- Bashir, I.; Khan, M.A.; Dilshad, E.; Siyo, B.; Hussain, E.; Ali, I. Antioxidant and anticancer silver nanoparticles of Mentha asiatica aerial part extract: A novel study. Inorg. Nano-Met. Chem. 2021, 1–7. [Google Scholar] [CrossRef]
- Al-Rajhi, A.M.H.; Salem, S.S.; Alharbi, A.A.; Abdelghany, T.M. Ecofriendly synthesis of silver nanoparticles using Kei-apple (Dovyalis caffra) fruit and their efficacy against cancer cells and clinical pathogenic microorganisms. Arab. J. Chem. 2022, 15, 103927. [Google Scholar] [CrossRef]
- Salem, S.S. Baker’s Yeast-Mediated Silver Nanoparticles: Characterisation and Antimicrobial Biogenic Tool for Suppressing Pathogenic Microbes. BioNanoScience 2022, 12, 1220–1229. [Google Scholar] [CrossRef]
- Aref, M.S.; Salem, S.S. Bio-callus synthesis of silver nanoparticles, characterization, and antibacterial activities via Cinnamomum camphora callus culture. Biocatal. Agric. Biotechnol. 2020, 27, 101689. [Google Scholar] [CrossRef]
- Soliman, M.K.Y.; Abu-Elghait, M.; Salem, S.S.; Azab, M.S. Multifunctional properties of silver and gold nanoparticles synthesis by Fusarium pseudonygamai. Biomass Convers. Biorefin. 2022, 1–18. [Google Scholar] [CrossRef]
- Salem, S.S.; Ali, O.M.; Reyad, A.M.; Abd-Elsalam, K.A.; Hashem, A.H. Pseudomonas indica-Mediated Silver Nanoparticles: Antifungal and Antioxidant Biogenic Tool for Suppressing Mucormycosis Fungi. J. Fungi 2022, 8, 126. [Google Scholar] [CrossRef]
- Alsharif, S.M.; Salem, S.S.; Abdel-Rahman, M.A.; Fouda, A.; Eid, A.M.; El-Din Hassan, S.; Awad, M.A.; Mohamed, A.A. Multifunctional properties of spherical silver nanoparticles fabricated by different microbial taxa. Heliyon 2020, 6, e03943. [Google Scholar] [CrossRef]
- Do Nascimento, E.M.M.; Rodrigues, F.F.G.; Campos, A.R.; Da Costa, J.G.M. Phytochemical prospection, toxicity and antimicrobial activity of Mentha arvensis (labiatae) from Northeast of Brazil. J. Young Pharm. 2009, 1, 210. [Google Scholar] [CrossRef]
- Moldovan, R.I.; Oprean, R.; Benedec, D.; Hanganu, D.; Duma, M.; Oniga, I.; Vlase, L. LC-MS analysis, antioxidant and antimicrobial activities for five species of Mentha cultivated in Romania. Dig. J. Nanomater. Biostruct. 2014, 9, 559–566. [Google Scholar]
- Aziz, W.J.; Jassim, H.A. Green Chemistry for the Preparation of Silver Nanoparticles Using Mint Leaf Leaves Extracts and Evaluation of their Antimicrobial Potential. World News Nat. Sci. 2018, 18, 163–170. [Google Scholar]
- Javed, B.; Nadhman, A.; Rehman, Z. Optimization, Characterization and Antimicrobial Activity of Silver Nanoparticles against Plant Bacterial Pathogens Phyto-synthesized by Mentha longifolia. Mater. Res. Express 2020, 7, 085406. [Google Scholar] [CrossRef]
- Harsha, L.; Jain, R.K.; Prasad, A.S. Synthesis, characterization, and antimicrobial activity of silver nanoparticles derived from Mentha X piperita + Ocimum tenuiflorum: An in vitro study. J. Adv. Pharm. Technol. Res. 2022, 13, S272–S276. [Google Scholar] [PubMed]
- Naghmouchi, S.; Al-Zaban, M.I.; Al-Zaben, M.; Alharbi, N.; Bahatheq, A. Generation and Characterization of Silver Nanoparticles in Mentha pulegium Extract and Evaluation of Biological Activities of the Prepared Extract. J. Nanomater. 2022, 2022, 5410274. [Google Scholar] [CrossRef]
- Patil, R.S.; Kokate, M.R.; Kolekar, S.S. Bioinspired synthesis of highly stabilized silver nanoparticles using Ocimum tenuiflorum leaf extract and their antibacterial activity. Spectrochim. Acta Part A Mol. Biomol. Spectrosc. 2012, 91, 234–238. [Google Scholar] [CrossRef]
- Lu, J.; Wang, Y.; Jin, M.; Yuan, Z.; Bond, P.; Guo, J. Both silver ions and silver nanoparticles facilitate the horizontal transfer of plasmid-mediated antibiotic resistance genes. Water Res. 2020, 169, 115229. [Google Scholar] [CrossRef]
- Mundlia, J.; Ahuja, M.; Kumar, P.; Pillay, V. Improved antioxidant, antimicrobial and anticancer activity of naringenin on conjugation with pectin. 3 Biotech 2019, 9, 312. [Google Scholar] [CrossRef]
- Xu, D.P.; Li, Y.; Meng, X.; Zhou, T.; Zhou, Y.; Zheng, J.; Zhang, J.J.; Li, H.B. Natural Antioxidants in Foods and Medicinal Plants: Extraction, Assessment and Resources. Int. J. Mol. Sci. 2017, 18, 96. [Google Scholar] [CrossRef]
- Qanash, H.; Yahya, R.; Bakri, M.M.; Bazaid, A.S.; Qanash, S.; Shater, A.F.; Abdelghant, T.M. Anticancer, antioxidant, antiviral and antimicrobial activities of Kei Apple (Dovyalis caffra) fruit. Sci. Rep. 2022, 12, 5914. [Google Scholar] [CrossRef]
- Al-Rajhi, A.M.H.; Ghany, T.M.A. Nanoemulsions of some edible oils and their antimicrobial, antioxidant, and anti-hemolytic activities. BioResources 2023, 18, 1465–1481. [Google Scholar] [CrossRef]
- Qanash, H.; Bazaid, A.S.; Alharazi, T.; Barnawi, H.; Alotaibi, K.; Shater, A.-R.M.; Abdelghany, T.M. Bioenvironmental applications of myco-created bioactive zinc oxide nanoparticle-doped selenium oxide nanoparticles. Biomass Convers. Biorefin. 2023, 1–12. [Google Scholar] [CrossRef]
- Khalid, A.; Ahmad, P.; Khandaker, M.U.; Modafer, Y.; Almukhlifi, H.A.; Bazaid, A.S.; Aldarhami, A.; Alanazi, A.M.; Jefri, O.A.; Uddin, M.; et al. Biologically Reduced Zinc Oxide Nanosheets Using Phyllanthus emblica Plant Extract for Antibacterial and Dye Degradation Studies. J. Chem. 2023, 2023, 3971686. [Google Scholar] [CrossRef]
- Parvekar, P.; Palaskar, J.; Metgud, S.; Maria, R.; Dutta, S. The minimum inhibitory concentration (MIC) and minimum bactericidal concentration (MBC) of silver nanoparticles against Staphylococcus aureus. Biomater. Investig. Dent. 2020, 7, 105–109. [Google Scholar] [CrossRef] [PubMed]
- Aldarhami, A.; Bazaid, A.S.; Alhamed, A.S.; Alghaith, A.F.; Ahamad, S.R.; Alassmrry, Y.A.; Alharazi, T.; Snoussi, M.; Qanash, H.; Alamri, A.; et al. Antimicrobial Potential of Pithecellobium dulce Seed Extract against Pathogenic Bacteria: In Silico and In Vitro Evaluation. BioMed Res. Int. 2023, 2023, 2848198. [Google Scholar] [CrossRef] [PubMed]
- Rajakumar, S.; Revanth, M.; Kasi, A.; Sujitha, P. Evaluating the antibacterial efficacy and minimal bactericidal concentration (MBC) of three different herbal extracts on recalcitrant endodontic pathogens—An in vitro study. J. Int. Oral Health 2022, 14, 266–272. [Google Scholar] [CrossRef]

| Compound | Retention Time | Area | Area (%) | Concentration (µg/mL) |
|---|---|---|---|---|
| Gallic acid | 3.367 | 221.00 | 3.60 | 966.93 |
| Chlorogenic acid | 4.242 | 1031.15 | 16.81 | 7144.66 |
| Catechin | 4.710 | 78.59 | 1.28 | 980.13 |
| Methyl gallate | 5.694 | 114.42 | 1.87 | 316.86 |
| Caffeic acid | 6.079 | 160.35 | 2.61 | 631.52 |
| Syringic acid | 6.388 | 107.35 | 1.75 | 379.83 |
| Rutin | 8.306 | 8.03 | 0.13 | 47.82 |
| Ellagic acid | 9.005 | 81.01 | 1.32 | 841.23 |
| Vanillin | 9.542 | 85.37 | 1.39 | 189.64 |
| Ferulic acid | 10.269 | 167.45 | 2.73 | 574.81 |
| Naringenin | 10.537 | 160.38 | 2.62 | 958.50 |
| Daidzein | 12.370 | 13.93 | 0.23 | 43.25 |
| Quercetin | 12.861 | 64.90 | 1.06 | 428.51 |
| Cinnamic acid | 14.207 | 11.1515 | 0.18 | 10.40 |
| Apigenin | 14.499 | 74.85 | 1.22 | 283.88 |
| Kaempferol | 15.050 | 156.56 | 2.55 | 570.72 |
| Hesperetin | 15.823 | 31.09 | 0.51 | 83.77 |
| Tested Organism | Mean Inhibition Zones (mm) | MIC (µg/mL) | MBC (µg/mL) | MBC/MIC Index | Mean Inhibition Zones (mm) of AgNO3 | |||||
|---|---|---|---|---|---|---|---|---|---|---|
| AgNPs | ME | Control * | AgNPs | ME | AgNPs | ME | AgNPs | ME | 200 µg/mL | |
| Bacillus subtilis | 33.67 ± 1.15 | 30.67 ± 0.58 | 30.17 ± 1.26 | 7.83 ± 0.06 | 15.70 ± 0.17 | 31.17 ± 0.14 | 31.83 ± 1.01 | 3.98 | 2.03 | 24.22 ± 1.15 |
| Enterococcus faecalis | 25.33 ± 1.53 | 24.33 ± 0.58 | 23.17 ± 0.29 | 15.53 ± 0.12 | 15.77 ± 0.15 | 31.37 ± 0.20 | 62.33 ± 0.29 | 2.02 | 3.95 | 14.33 ± 1.53 |
| Escherichia coli | 30.00 ± 1.73 | 27.83 ± 0.29 | 30.33 ± 0.29 | 7.73 ± 0.12 | 7.87 ± 0.06 | 7.90 ± 0.17 | 15.50 ± 0.17 | 1.02 | 1.97 | 21. 33 ± 1.53 |
| Proteus vulgaris | 32.33 ± 1.53 | 29.67 ± 0.58 | 26.00 ± 0.50 | 15.57 ± 0.06 | 7.90 ± 0.10 | 15.70 ± 0.17 | 15.67 ± 0.12 | 1.01 | 1.98 | 20.33 ± 1.15 |
| Candida albicans | 27.50 ± 0.87 | 22.83 ± 0.29 | 22.17 ± 0.29 | 31.33 ± 0.14 | 62.67 ± 0.29 | 63.0 ± 0.87 | 124.33 ± 1.15 | 0.02 | 1.98 | 16.00 ± 1.00 |
| Aspergillus flavus | NA | NA | 17.33 ± 0.58 | - | - | - | - | - | - | NA |
| Concentration (µg/mL) | Ascorbic Acid | ME | AgNPs | |||
|---|---|---|---|---|---|---|
| DPPH Scavenging (%) | SD | DPPH Scavenging (%) | SD | DPPH Scavenging (%) | SD | |
| 1000 | 95.5 | 0.002 | 92.1 | 0.002 | 93.7 | 0.003 |
| 500 | 92.9 | 0.004 | 85.6 | 0.002 | 88.6 | 0.002 |
| 250 | 91.1 | 0.005 | 79.3 | 0.002 | 83.0 | 0.003 |
| 125 | 84.9 | 0.006 | 72.6 | 0.004 | 76.3 | 0.001 |
| 62.50 | 76.4 | 0.006 | 65.7 | 0.004 | 69.9 | 0.003 |
| 31.25 | 69.6 | 0.004 | 59.5 | 0.001 | 63.2 | 0.005 |
| 15.63 | 62.6 | 0.005 | 52.1 | 0.007 | 56.1 | 0.006 |
| 7.81 | 54.7 | 0.003 | 45.5 | 0.003 | 48.5 | 0.004 |
| 3.90 | 44.3 | 0.002 | 35.8 | 0.006 | 41.6 | 0.005 |
| 1.95 | 40.2 | 0.007 | 30.5 | 0.004 | 35.0 | 0.011 |
| 0 | 0.0 | 0.004 | 0.0 | 0.016 | 0.0 | 0.016 |
| IC50 | 3.45 µg/mL | 13.42 µg/mL | 8.73 µg/mL | |||
Disclaimer/Publisher’s Note: The statements, opinions and data contained in all publications are solely those of the individual author(s) and contributor(s) and not of MDPI and/or the editor(s). MDPI and/or the editor(s) disclaim responsibility for any injury to people or property resulting from any ideas, methods, instructions or products referred to in the content. |
© 2023 by the authors. Licensee MDPI, Basel, Switzerland. This article is an open access article distributed under the terms and conditions of the Creative Commons Attribution (CC BY) license (https://creativecommons.org/licenses/by/4.0/).
Share and Cite
Qanash, H.; Bazaid, A.S.; Binsaleh, N.K.; Alharbi, B.; Alshammari, N.; Qahl, S.H.; Alhuthali, H.M.; Bagher, A.A. Phytochemical Characterization of Saudi Mint and Its Mediating Effect on the Production of Silver Nanoparticles and Its Antimicrobial and Antioxidant Activities. Plants 2023, 12, 2177. https://doi.org/10.3390/plants12112177
Qanash H, Bazaid AS, Binsaleh NK, Alharbi B, Alshammari N, Qahl SH, Alhuthali HM, Bagher AA. Phytochemical Characterization of Saudi Mint and Its Mediating Effect on the Production of Silver Nanoparticles and Its Antimicrobial and Antioxidant Activities. Plants. 2023; 12(11):2177. https://doi.org/10.3390/plants12112177
Chicago/Turabian StyleQanash, Husam, Abdulrahman S. Bazaid, Naif K. Binsaleh, Bandar Alharbi, Nawaf Alshammari, Safa H. Qahl, Hayaa M. Alhuthali, and Abdullatiff A. Bagher. 2023. "Phytochemical Characterization of Saudi Mint and Its Mediating Effect on the Production of Silver Nanoparticles and Its Antimicrobial and Antioxidant Activities" Plants 12, no. 11: 2177. https://doi.org/10.3390/plants12112177
APA StyleQanash, H., Bazaid, A. S., Binsaleh, N. K., Alharbi, B., Alshammari, N., Qahl, S. H., Alhuthali, H. M., & Bagher, A. A. (2023). Phytochemical Characterization of Saudi Mint and Its Mediating Effect on the Production of Silver Nanoparticles and Its Antimicrobial and Antioxidant Activities. Plants, 12(11), 2177. https://doi.org/10.3390/plants12112177

